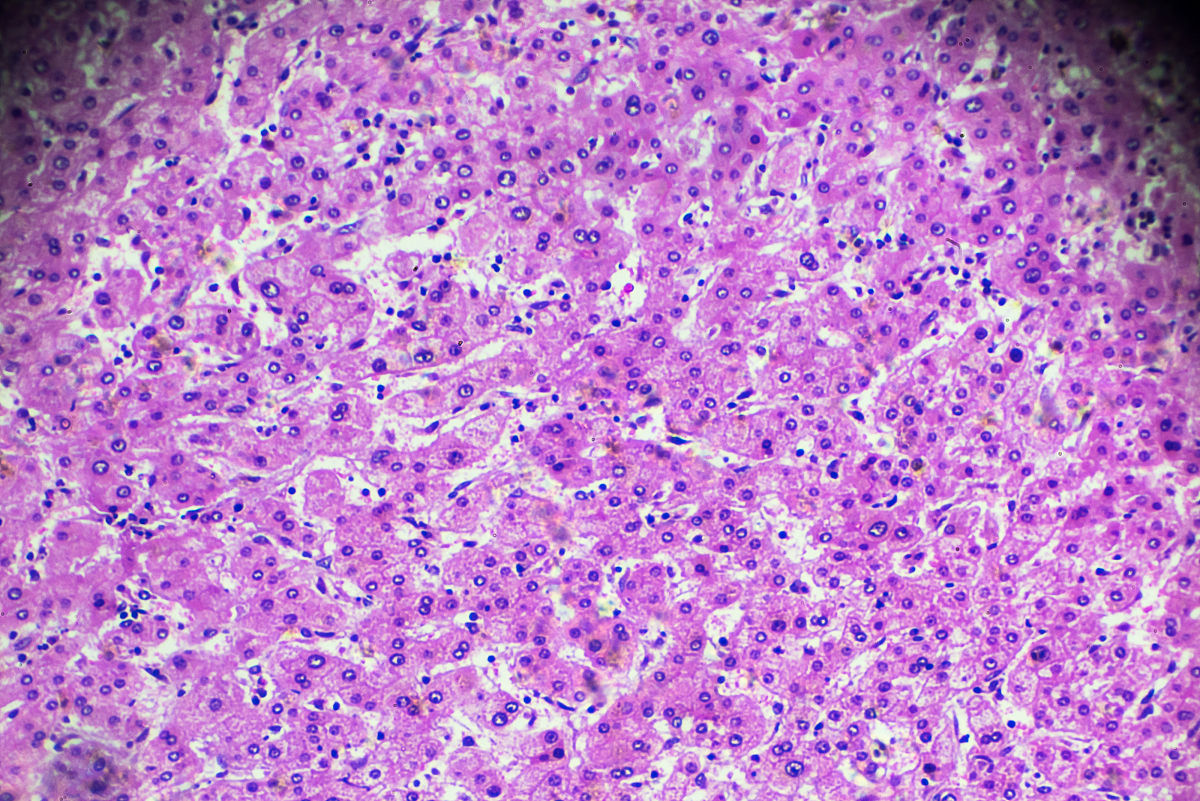
HCC组织模型评分显著区别于正常肝组织

HCC组织模型评分显著区别于正常肝组织
HCC\u7ec4\u7ec7\u4e0e\u6b63\u5e38\u809d\u7ec4\u7ec7\u7684\u6a21\u578b\u8bc4\u5206\u5b58\u5728\u663e\u8457\u5dee\u522b\u3002

原文地址: https://www.cveoy.top/t/topic/pZwf 著作权归作者所有。请勿转载和采集!
安全问答是一个知识全球问答,包含丰富的问答知识
HCC\u7ec4\u7ec7\u4e0e\u6b63\u5e38\u809d\u7ec4\u7ec7\u7684\u6a21\u578b\u8bc4\u5206\u5b58\u5728\u663e\u8457\u5dee\u522b\u3002
原文地址: https://www.cveoy.top/t/topic/pZwf 著作权归作者所有。请勿转载和采集!